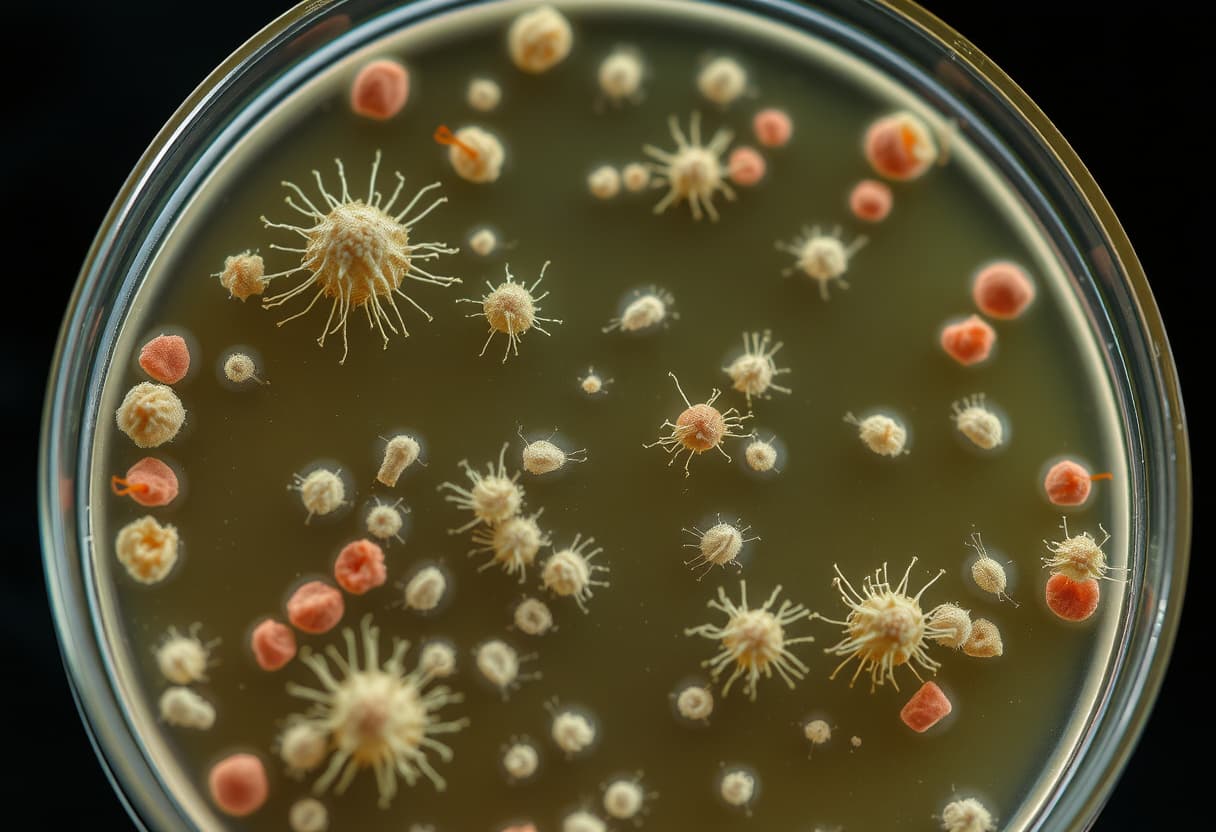
Antibiotic Resistance: How Bacteria Evolve and Why It's a Global Crisis

Antibiotic Resistance: How Bacteria Evolve and Why It's a Global Crisis
Antibiotic resistance is one of the most significant public health threats of the twenty-first century — and it is fundamentally an evolutionary problem. Here's how bacteria develop resistance, why it spreads, and what is being done about it.
February 23, 2026

🌱
🌱 Premium Content
This article is for Seedling and Deep Roots members. Start a 7-day free trial to unlock all premium articles across every category.